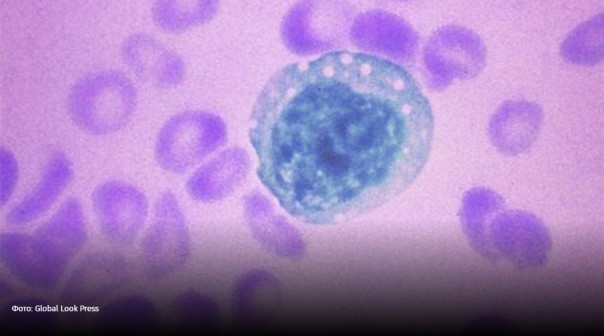

Злой Ханта: эксперты рассказали, чего ждать от нового вируса
В России есть быстрые тесты и вакцина от мышиного штамма
Случай в китайской провинции Юньнань, где у умершего в автобусе мужчины после вскрытия был обнаружен хантавирус, заставил ученых задуматься о новой угрозе. Россия занимает второе место после Китая по количеству подтвержденных случаев геморрагической лихорадки, вызванной хантавирусами.
Для отечественных эпидемиологов этот патоген является знакомым и давно изученным, рассказали в Федеральном научном центре исследований и разработки иммунобиологических препаратов им. М.П. Чумакова РАН. В нашей стране созданы быстрые тесты и вакцина для его лечения. Правда, пока она еще не прошла клинические испытания.
Случай в автобусе
Внезапно рухнувший замертво в автобусе в китайской провинции Юньнань мужчина взволновал весь мир. В крови у него нашли не коронавирус, как можно было бы предположить, а хантавирус — особый патоген, который распространяется только на территории некоторых стран. Он вызывает геморрагическую лихорадку с почечным синдромом — это такой вид болезненного состояния, которое сопровождается высокой температурой, внутренними кровотечениями и отказом почек.
— Территория Китая эндемична (специфична) по хантавирусам, — сообщил руководитель научного направления Федерального научного центра исследований и разработки иммунобиологических препаратов им. М.П. Чумакова РАН Евгений Ткаченко. — Такие случаи, как тот, что случился с мужчиной в автобусе, китайским врачам известны, они хорошо знают симптоматику. Поэтому удалось быстро провести нужный тест и выявить патоген.
Иногда, как говорят специалисты, при отсутствии лечения в стационаре у зараженного может резко развиться ДВС-синдром (диссеминированное внутрисосудистое свертывание или образование тромбов. — Ред.), а также полиорганная недостаточность. Сильнее всего про этом страдают почки. Может произойти даже разрыв одной из них, а также ишемический инфаркт, что, возможно, и стало причиной летального исхода в провинции Юньнань.
— Возбудитель заболевания — хантавирус относится к роду вирусов человека и животных из семейства Hantaviridae, — рассказал сотрудник Института биологии ТюмГУ Николай Карпов.
— Опасность зависит от конкретного штамма и состояния иммунной системы. Считается, что хантавирусы не передаются от человека к человеку, — подчеркнул эксперт.
По распространенности данных патогенов первое место в мире занимает именно Китай, поэтому у них проводится вакцинация, а также существуют быстрые тесты для выявления данной инфекции. Вирус передается в основном от грызунов трех разных подсемейств: мышей, полевок и хомяков. Однако известны случаи и передачи от летучих мышей — воздушно-пылевым путем.
— Заражаются в основном дачники и сельские жители путем вдыхания пыли от высохших экскрементов определенных видов лесных мелких грызунов, в просторечье собирательно называемых мышами, — пояснил член-корреспондент РАН, заведующий лабораторией биотехнологии и вирусологии НГУ Сергей Нетесов. — При стационарном лечении, как правило, человек выздоравливает.
Российский путь
Наша страна находится на втором месте в мире по фиксации заболеваний, вызываемых хантавирусами. В России в число особо опасных регионов входят Поволжье, Башкортостан и Сочи.
Особенно тяжелая ситуация сложилась в 2019 году, зимой, в Саратовской области. В природном парке «Кумысная долина» заразилось около 3 тыс. человек. Были и летальные исходы.
— Несомненно, хантавирусом заражается меньшее количество людей, нежели коронавирусом, — отметил Евгений Ткаченко. — Но пандемия пройдет, а ежегодная ситуация с геморрагической лихорадкой останется. Поэтому так важно провести клинические испытания нашей вакцины и иметь ее запас на будущее. Китайский препарат нам не подходит, так как у них абсолютно другие вирусы, — подчеркнул эксперт.
Последствия после перенесенной болезни, по словам Евгения Ткаченко, могут быть крайне серьезными. Часто развивается астенический синдром, и такое состояние может продлиться целый год. Иногда, как отмечает эксперт, у мужчин наступает временная импотенция. Это особенно «бьет» по молодым, ведь именно они бывают больше всего подвержены болезни. Две трети пациентов с геморрагической лихорадкой, вызванной штаммом, мужчины.
Также, по словам эксперта, всё же существуют хантавирусы, которые передаются от человека к человеку.
— В Южной Америке есть один хантавирус, у которого была замечена передача от человека к человеку, — подчеркнул Евгений Ткаченко. — Там этот патоген вызывает тяжелое заболевание с большой летальностью, она доходит до 50%. На сегодняшний день описано уже несколько случаев заражения медицинского персонала при уходе за такими больными.
С Евгением Ткаченко согласен и заведующий инфекционным отделением университетской клиники H-Clinic РУДН Данила Коннов. Впрочем, считает эксперт, все эти факты не имеют эпидемиологического значения.
— Хотя описание единичных случаев передачи от человека к человеку периодически встречаются в литературе, основными источниками и резервуарами инфекции всё же остаются грызуны. Препаратов, показавших высокую эффективность в лечении хантавирусных инфекций, в настоящий момент не существует, хотя некоторую эффективность продемонстрировало назначение противовирусного препарата рибавирин, — отметил ученый.
Пандемичное распространение хантавируса может произойти лишь в том случае, если мутации патогена позволят ему получить новые свойства — передаваться от человека к человеку. Но данных о таких тенденциях в настоящий момент нет.
В России уже имеется быстрый тест на хантавирусную инфекцию, который дает ответ в течение часа.
Анна Урманцева, Мария Недюк
Случай в китайской провинции Юньнань, где у умершего в автобусе мужчины после вскрытия был обнаружен хантавирус, заставил ученых задуматься о новой угрозе. Россия занимает второе место после Китая по количеству подтвержденных случаев геморрагической лихорадки, вызванной хантавирусами.
Для отечественных эпидемиологов этот патоген является знакомым и давно изученным, рассказали в Федеральном научном центре исследований и разработки иммунобиологических препаратов им. М.П. Чумакова РАН. В нашей стране созданы быстрые тесты и вакцина для его лечения. Правда, пока она еще не прошла клинические испытания.
Случай в автобусе
Внезапно рухнувший замертво в автобусе в китайской провинции Юньнань мужчина взволновал весь мир. В крови у него нашли не коронавирус, как можно было бы предположить, а хантавирус — особый патоген, который распространяется только на территории некоторых стран. Он вызывает геморрагическую лихорадку с почечным синдромом — это такой вид болезненного состояния, которое сопровождается высокой температурой, внутренними кровотечениями и отказом почек.
— Территория Китая эндемична (специфична) по хантавирусам, — сообщил руководитель научного направления Федерального научного центра исследований и разработки иммунобиологических препаратов им. М.П. Чумакова РАН Евгений Ткаченко. — Такие случаи, как тот, что случился с мужчиной в автобусе, китайским врачам известны, они хорошо знают симптоматику. Поэтому удалось быстро провести нужный тест и выявить патоген.
Иногда, как говорят специалисты, при отсутствии лечения в стационаре у зараженного может резко развиться ДВС-синдром (диссеминированное внутрисосудистое свертывание или образование тромбов. — Ред.), а также полиорганная недостаточность. Сильнее всего про этом страдают почки. Может произойти даже разрыв одной из них, а также ишемический инфаркт, что, возможно, и стало причиной летального исхода в провинции Юньнань.
— Возбудитель заболевания — хантавирус относится к роду вирусов человека и животных из семейства Hantaviridae, — рассказал сотрудник Института биологии ТюмГУ Николай Карпов.
— Опасность зависит от конкретного штамма и состояния иммунной системы. Считается, что хантавирусы не передаются от человека к человеку, — подчеркнул эксперт.
По распространенности данных патогенов первое место в мире занимает именно Китай, поэтому у них проводится вакцинация, а также существуют быстрые тесты для выявления данной инфекции. Вирус передается в основном от грызунов трех разных подсемейств: мышей, полевок и хомяков. Однако известны случаи и передачи от летучих мышей — воздушно-пылевым путем.
— Заражаются в основном дачники и сельские жители путем вдыхания пыли от высохших экскрементов определенных видов лесных мелких грызунов, в просторечье собирательно называемых мышами, — пояснил член-корреспондент РАН, заведующий лабораторией биотехнологии и вирусологии НГУ Сергей Нетесов. — При стационарном лечении, как правило, человек выздоравливает.
Российский путь
Наша страна находится на втором месте в мире по фиксации заболеваний, вызываемых хантавирусами. В России в число особо опасных регионов входят Поволжье, Башкортостан и Сочи.
Особенно тяжелая ситуация сложилась в 2019 году, зимой, в Саратовской области. В природном парке «Кумысная долина» заразилось около 3 тыс. человек. Были и летальные исходы.
— Несомненно, хантавирусом заражается меньшее количество людей, нежели коронавирусом, — отметил Евгений Ткаченко. — Но пандемия пройдет, а ежегодная ситуация с геморрагической лихорадкой останется. Поэтому так важно провести клинические испытания нашей вакцины и иметь ее запас на будущее. Китайский препарат нам не подходит, так как у них абсолютно другие вирусы, — подчеркнул эксперт.
Последствия после перенесенной болезни, по словам Евгения Ткаченко, могут быть крайне серьезными. Часто развивается астенический синдром, и такое состояние может продлиться целый год. Иногда, как отмечает эксперт, у мужчин наступает временная импотенция. Это особенно «бьет» по молодым, ведь именно они бывают больше всего подвержены болезни. Две трети пациентов с геморрагической лихорадкой, вызванной штаммом, мужчины.
Также, по словам эксперта, всё же существуют хантавирусы, которые передаются от человека к человеку.
— В Южной Америке есть один хантавирус, у которого была замечена передача от человека к человеку, — подчеркнул Евгений Ткаченко. — Там этот патоген вызывает тяжелое заболевание с большой летальностью, она доходит до 50%. На сегодняшний день описано уже несколько случаев заражения медицинского персонала при уходе за такими больными.
С Евгением Ткаченко согласен и заведующий инфекционным отделением университетской клиники H-Clinic РУДН Данила Коннов. Впрочем, считает эксперт, все эти факты не имеют эпидемиологического значения.
— Хотя описание единичных случаев передачи от человека к человеку периодически встречаются в литературе, основными источниками и резервуарами инфекции всё же остаются грызуны. Препаратов, показавших высокую эффективность в лечении хантавирусных инфекций, в настоящий момент не существует, хотя некоторую эффективность продемонстрировало назначение противовирусного препарата рибавирин, — отметил ученый.
Пандемичное распространение хантавируса может произойти лишь в том случае, если мутации патогена позволят ему получить новые свойства — передаваться от человека к человеку. Но данных о таких тенденциях в настоящий момент нет.
В России уже имеется быстрый тест на хантавирусную инфекцию, который дает ответ в течение часа.
Анна Урманцева, Мария Недюк
Новостной сайт E-News.su | E-News.pro. Используя материалы, размещайте обратную ссылку.
Оказать финансовую помощь сайту E-News.su | E-News.pro
Если заметили ошибку, выделите фрагмент текста и нажмите Ctrl+Enter (не выделяйте 1 знак)